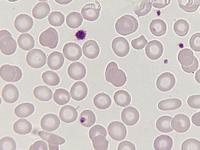

Normale Thrombozyten, Blutausstrich, panoptische Färbung (Objektiv 40x). Die Thrombozyten liegen einzeln, nur selten findet man zwei aneinander liegend. Größere Haufen von Thrombozyten sollten an das Bild einer Pseudothrombozytopenie denken lassen. Die Durchmesser der bei dieser Vergrößerung eindeutig als Thrombozyten auszumachenden Zellen reichen in diesem Blickfeld unter dieser Vergrößerung von etwa 1,5 bis 3 µm. Kleinere Partikel können auch Verunreinungen oder sonstige Auffälligkeiten sein (z.B. Erythrozyteninklusionen).

|
|
|
|